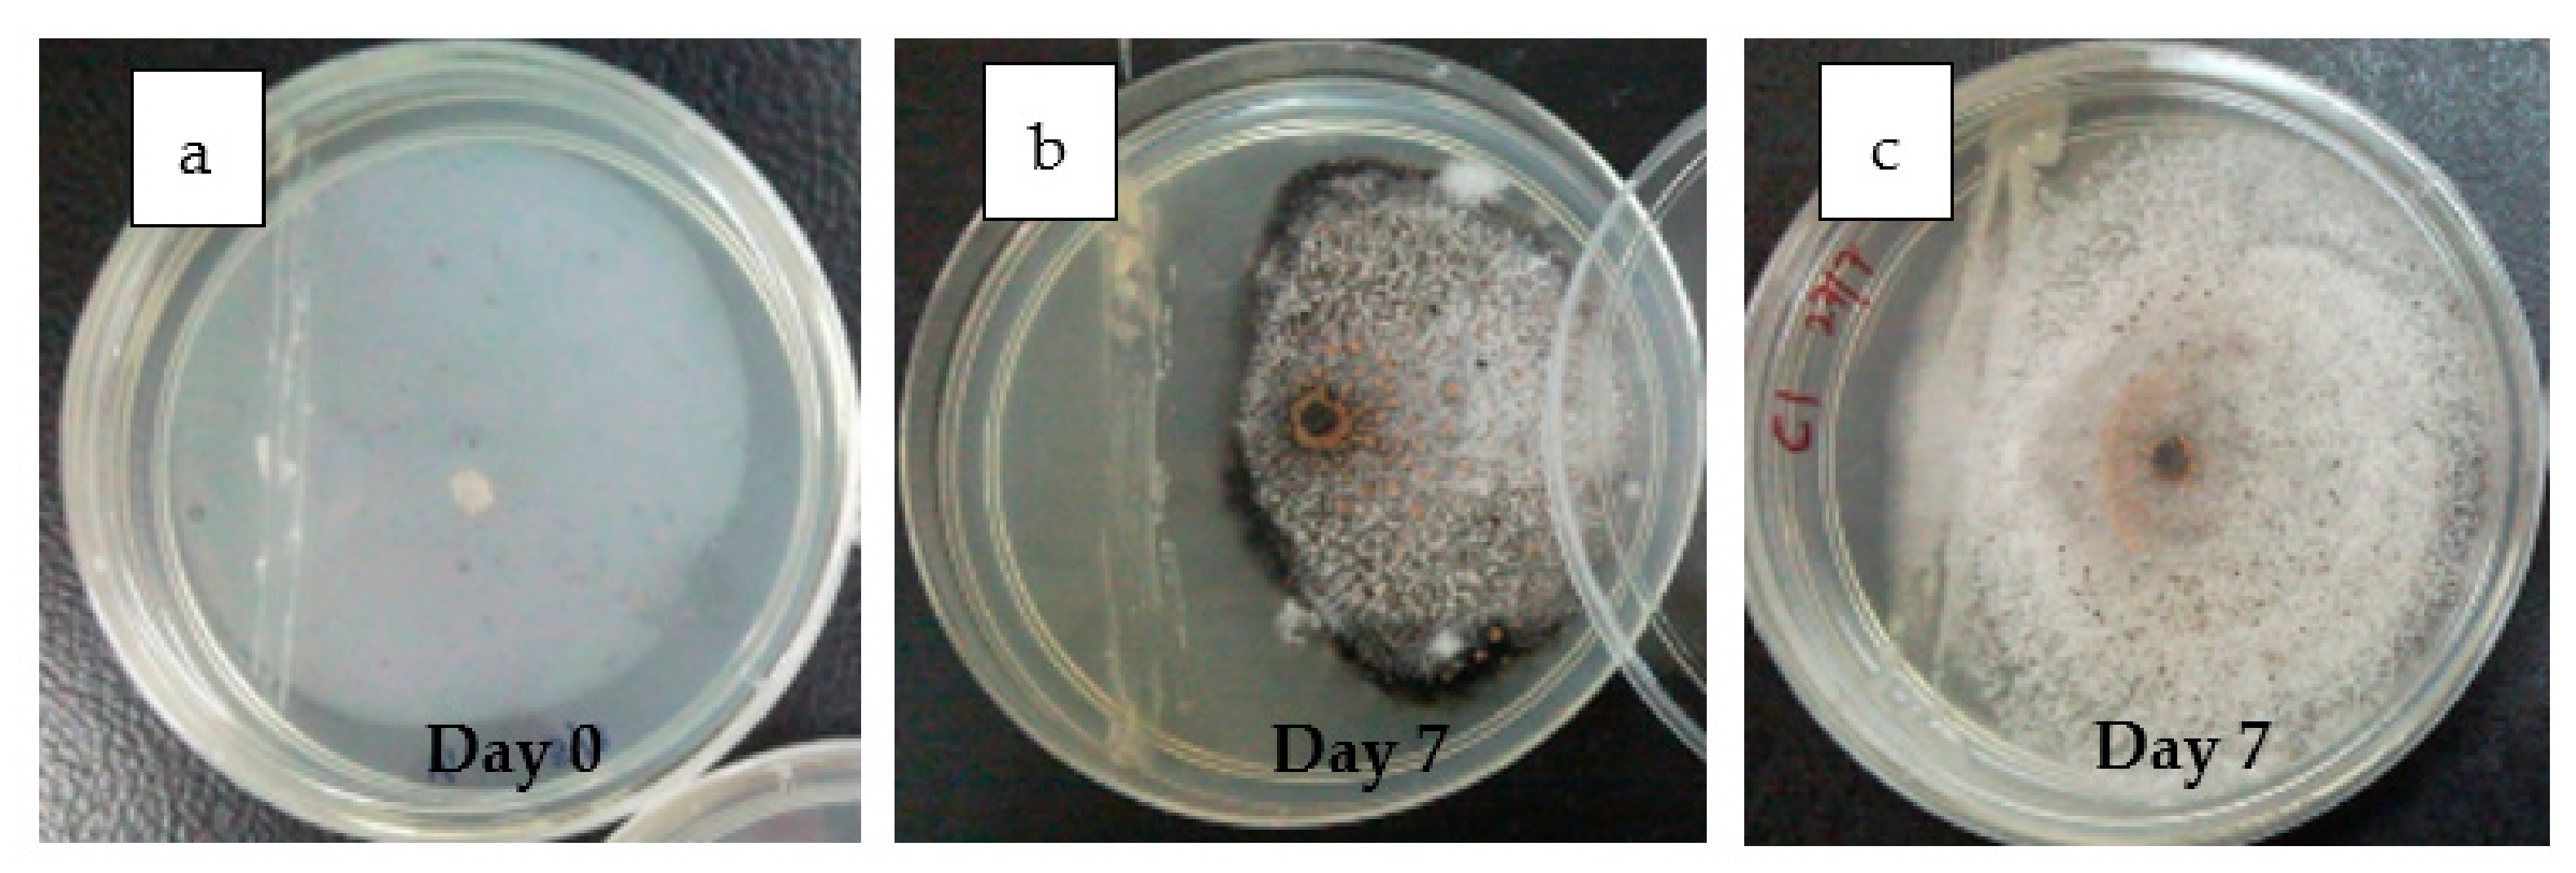
Agronomy 11 00760 g001
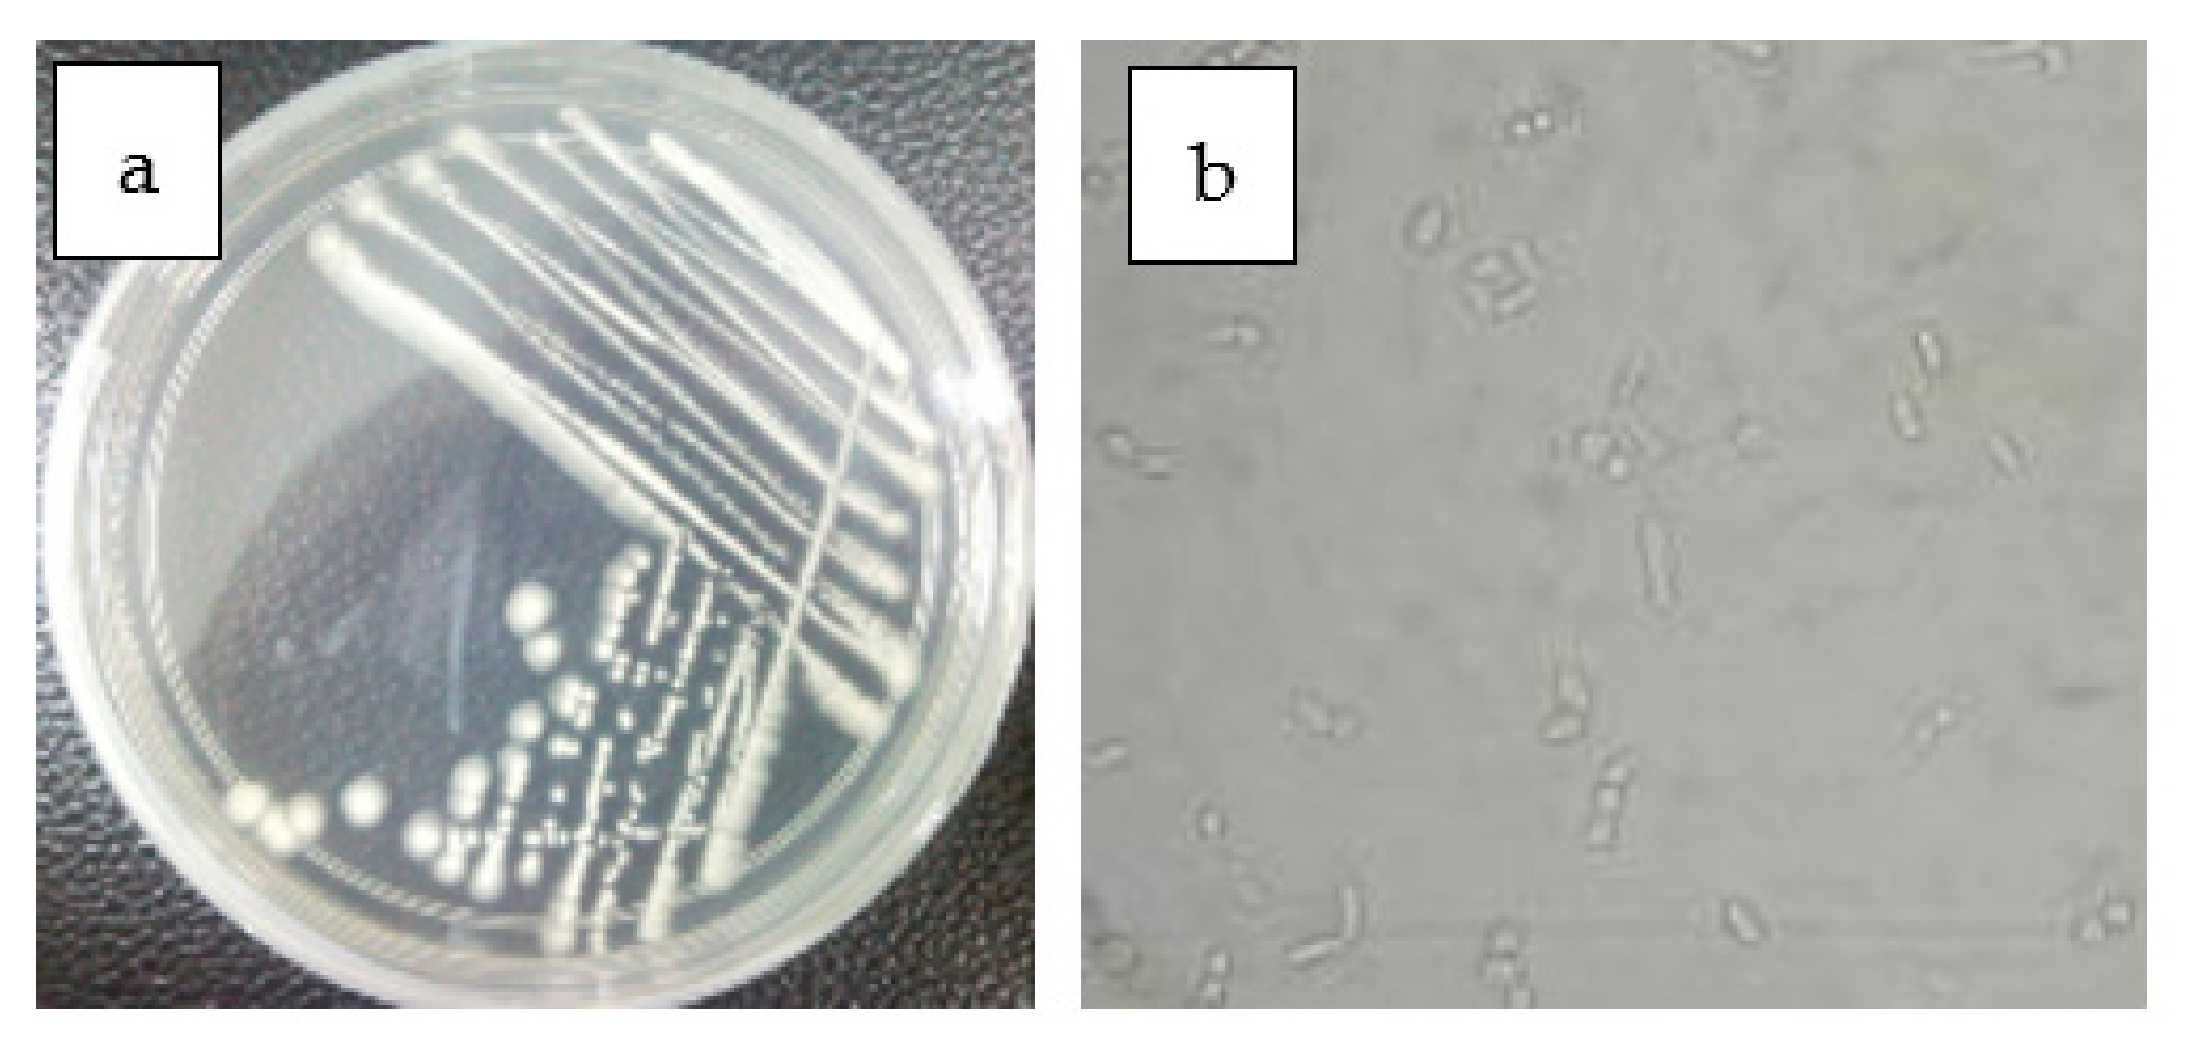
Agronomy 11 00760 g004

Selecting Antagonistic Yeast for Postharvest Biocontrol of Colletotrichum gloeosporioides in Papaya Fruit and Possible Mechanisms Involved
Abstract
1. Introduction
2. Materials and Methods
2.1. Isolation of Antagonistic Yeast
2.2. Screening of Antagonist Yeast
2.2.1. Dual Culture Assay
2.2.2. Agar Well Test
2.2.3. In Vivo Assay
2.2.4. Inhibition of C. gloeosporioides Spore Germination
2.2.5. Production of Diffusible Antagonist Substance
2.3. Identification of Antagonistic Yeast
2.4. In Vivo Efficacy of Selected Antagonistic Yeast in Controlling Anthracnose Disease in Papaya Fruit
2.5. Effects of Yeast Application on Selected Defensive Enzyme Activities
2.5.1. Tissue Extraction and Determination of Polyphenol Oxidase (PPO) Enzyme Activities
2.5.2. Tissue Extraction and Determination of Phenylalanine Ammonia-Lyase (PAL) Enzyme Activities
2.5.3. Tissue Extraction and Determination of Catalase (CAT) Enzyme Activities
2.6. Yeast Interaction and Attachment to the Pathogen and Papaya Peel
2.7. Experimental Design and Statistical Analysis
3. Results
3.1. Isolation of Antagonistic Yeast from the Papaya Plant
3.2. Screening of Antagonist Yeast Against C. gloeosporioides
3.3. Effect of Yeast Suspension on C. gloeosporioides Growth in Agar Well Test
3.4. Effect of Antagonist Yeast on In Vivo Anthracnose Disease Control
3.5. Effects of Antagonist Yeast Concentrations on C. gloeosporioides Spore Germination
3.6. Diffusible Compound Production by Antagonist Yeast
3.7. Antagonist Yeast Identification
3.8. Disease Incidence and Severity in Papaya Treated with Antagonist Yeast
3.9. Polyphenol Oxidase (PPO), Phenylalanine Ammonia-Lyase (PAL), Catalase (CAT) Enzyme Activity
3.10. Interaction of Antagonist Yeast and C. gloeosporioides in Papaya
4. Discussion
Author Contributions
Funding
Data Availability Statement
Acknowledgments
Conflicts of Interest
References
- Rahman, M.A.; Mahmud, T.M.M.; Kadir, J.; Abdul-Rahman, R.; Begum, M.M. Major postharvest fungal diseases of papaya cv. Sekaki in Selangor, Malaysia. Pertanika J. Trop. Agric. Sci. 2008, 31, 27–34. [Google Scholar]
- Capdeville, G.D., Jr.; Souza, M.T.; Santos, J.R.P.; Miranda, S.d.P.; Caetano, A.R.; Torres, F.A.G. Selection and testing of epiphytic yeasts to control anthracnose in post-harvest of papaya fruit. Sci. Hortic. 2007, 111, 179–185. [Google Scholar] [CrossRef]
- Paiva, E.D.; Serradilla, M.J.; Ruiz-Moyano, S.; Córdoba, M.G.; Villalobos, M.C.; Casquete, R.; Hernández, A. Combined effect of antagonistic yeast and modified atmosphere to control Penicillium expansum infection in sweet cherries cv. Ambrunés. Int. J. Food Microbiol. 2017, 241, 276–282. [Google Scholar] [CrossRef] [PubMed]
- Hernandez-Montiel, L.G.; Gutierrez-Perez, E.D.; Murillo-Amador, B.; Vero, S.; Chiquito-Contreras, R.G.; Rincon-Enriquez, G. Mechanisms employed by Debaryomyces hansenii in biological control of anthracnose disease on papaya fruit. Postharvest Biol. Technol. 2018, 139, 31–37. [Google Scholar] [CrossRef]
- Manso, T.; Nunes, C. Metschnikowia andauensis as a new biocontrol agent of fruit postharvest diseases. Postharvest Biol. Technol. 2011, 61, 64–71. [Google Scholar] [CrossRef]
- Carmona-Hernandez, S.; Reyes-Pérez, J.J.; Chiquito-Contreras, R.G.; Rincon-Enriquez, G.; Cerdan-Cabrera, C.R.; Hernandez-Montiel, L.G. Biocontrol of Postharvest Fruit Fungal Diseases by Bacterial Antagonists: A Review. Agronomy 2019, 9, 121. [Google Scholar] [CrossRef]
- Spadaro, D.; Droby, S. Development of biocontrol products for postharvest diseases of fruit: The importance of elucidating the mechanisms of action of yeast antagonists. Trends Food Sci. Technol. 2016, 47, 39–49. [Google Scholar] [CrossRef]
- Liu, J.; Sui, Y.; Wisniewski, M.; Droby, S.; Liu, Y. Review: Utilization of antagonistic yeasts to manage postharvest fungal diseases of fruit. Int. J. Food Microbiol. 2013, 167, 153–160. [Google Scholar] [CrossRef] [PubMed]
- Droby, S.; Wisniewski, M.; Macarisin, D.; Wilson, C. Twenty years of postharvest biocontrol research: Is it time for a new paradigm? Postharvest Biol. Technol. 2009, 52, 137–145. [Google Scholar] [CrossRef]
- Wilson, C.L.; Wisniewski, M.E. Biological control of postharvest diseases of fruit and vegetables: An emerging technology. Annu. Rev. Phytopathol. 1989, 27, 425–441. [Google Scholar] [CrossRef]
- Konsue, W.; Dethoup, T.; Limtong, S. Biological Control of Fruit Rot and Anthracnose of Postharvest Mango by Antagonistic Yeasts from Economic Crops Leaves. Microorganisms 2020, 8, 317. [Google Scholar] [CrossRef]
- El-Tarabily, K.A.; Sivasithamparam, K. Potential of yeasts as biocontrol agents of soil-borne fungal plant pathogens and as plant growth promoters. Mycoscience 2006, 47, 25–35. [Google Scholar] [CrossRef]
- Droby, S.; Chalutz, E. Mode of action of biocontrol agents for postharvest diseases. In Biological Control of Postharvest Diseases of Fruits and Vegetables-Theory and Practice; Wilson, C.L., Wisniewski, M.E., Eds.; CRC Press: Boca Raton, FL, USA, 1994. [Google Scholar]
- Arras, G.; Arru, S. Mechanisms of action of some microbial antagonists against fungal pathogens. Ann. Microbiol. Enzimol. 1997, 47, 97–120. [Google Scholar]
- Hasan, M.F. Controlling Anthracnose and Postharvest Quality of Papaya (Carica papaya cv. Frangi) Using Bacillus subtilis Strain B34. Ph.D. Thesis, Universiti Putra Malaysia, Selangor, Malaysia, 2012. [Google Scholar]
- Sariah, M. Potential of Bacillus spp. as a biocontrol agent for anthracnose fruit rot of chilli. Malays. Appl. Biol. 1994, 23, 53–60. [Google Scholar]
- Chanchaichaovivat, A.; Ruenwongsa, P.; Panijpan, B. Screening and identification of yeast strains from fruits and vegetables: Potential for biological control of postharvest chilli anthracnose (Colletotrichum capsici). Biol. Control 2007, 42, 326–335. [Google Scholar] [CrossRef]
- Zheng, M.; Shi, J.; Shi, J.; Wang, Q.; Li, Y. Antimicrobial effects of volatiles produced by two antagonistic Bacillus strains on the anthracnose pathogen in postharvest mangos. Biol. Control. 2013, 65, 200–206. [Google Scholar] [CrossRef]
- Al Zaemey, A.B.; Magan, N.; Thompson, A.K. Studies on the effect of fruit-coating polymers and organic acids on growth of Colletotrichum musae in vitro and on postharvest control of anthracnose of bananas. Mycol. Res. 1993, 97, 1463–1468. [Google Scholar] [CrossRef]
- Droby, S.; Wisniewski, M.E.; Cohen, L.; Weiss, B.; Touitou, D.; Eilam, Y. Influence of CaCl2 on Penicillium digitatum, grapefruit peel tissue, and biocontrol activity of Pichia guilliermondii. Phytopathology 1997, 87, 310–315. [Google Scholar] [CrossRef]
- Rahman, M.A.; Kadir, J.; Mahmud, T.M.M.; Abdul-Rahman, R.; Begum, M.M. Screening of Antagonistic Bacteria for Biocontrol Activities on Colletotrichum gloeosporioides in Papaya. Asian J. Plant Sci. 2007, 6, 12–20. [Google Scholar] [CrossRef]
- Edwards, K.; Johnstone, C.; Thompson, C. A simple and rapid method for the preparation of genomic plant DNA for PCR analysis. Nucleic Acids Res. 1991, 19, 1349. [Google Scholar] [CrossRef]
- White, T.J.; Bruns, T.; Lee, S.; Taylor, J. Amplification and direct sequencing of fungal ribosomal RNA genes for phylogenetics. In PCR Protocols: A Guide to Methods and Applications; Innis, M.A., Gelfand, D.H., Snisky, J.J., White, T.J., Eds.; Academic Press: San Diego, CA, USA, 1990. [Google Scholar]
- Hata, E.M.; Sijam, K.; Ahmad, Z.A.M.; Yusof, M.T.; Azman, N.A. In vitro Antimicrobial Assay of Actinomycetes in Rice against Xanthomonas oryzae pv oryzicola and as Potential Plant Growth Promoter. Braz. Arch. Biol. Technol. 2015, 58, 821–832. [Google Scholar] [CrossRef]
- Nghia, N.A.; Kadir, J.; Sunderasan, E.; Abdullah, M.P.; Malik, A.; Napis, S. Morphological and Inter Simple Sequence Repeat (ISSR) Markers Analyses of Corynespora cassiicola Isolates from Rubber Plantations in Malaysia. Mycopathologia 2008, 166, 189–201. [Google Scholar] [CrossRef]
- Shahnazi, S. Biological Characterization and Genetic Diversity of Fusarium spp. Associated with Yellowing Disease in Black Pepper (Piper nigrum L.) in Malaysia. Ph.D. Thesis, Universiti Putra Malaysia, Selangor, Malaysia, 2012. [Google Scholar]
- Tamura, K.; Stecher, G.; Peterson, D.; Filipski, A.; Kumar, S. MEGA6: Molecular Evolutionary Genetics Analysis Version 6.0. Mol. Biol. Evol. 2013, 30, 2725–2729. [Google Scholar] [CrossRef]
- Illeperuma, C.K.; Jayasuriya, P. Prolonged storage of ‘Karuthacolomban’ mango by modified atmosphere packaging at low temperature. J. Hortic. Sci. Biotech. 2002, 77, 153–157. [Google Scholar] [CrossRef]
- Singh, V.; Deverall, B.J. Bacillus subtilis as a control agent against fungal pathogens of citrus fruit. Trans. Br. Mycol. Soc. 1984, 83, 487–490. [Google Scholar] [CrossRef]
- Venkatachalam, K.; Meenune, M. Changes in physiochemical quality and browning related enzyme activity of longkong fruit during four different weeks of on-tree maturation. Food Chem. 2012, 131, 1437–1442. [Google Scholar] [CrossRef]
- Tian, S.P.; Xu, Y.; Jiang, A.L.; Gong, Q.Q. Physiological and quality responses of longan fruit to high O2 or high CO2 atmospheres in storage. Postharvest Biol. Technol. 2002, 24, 335–340. [Google Scholar] [CrossRef]
- Kokkinakis, D.M.; Brooks, J.L. Tomato peroxidases: Purification, characterization and catalytic properties. Plant Physiol. 1979, 63, 93–99. [Google Scholar] [CrossRef] [PubMed]
- Jiang, Y.M.; Joyce, D.C. ABA effects on ethylene production, PAL activity, anthocyanin and phenolic contents of strawberry fruit. Plant Growth Regul. 2003, 39, 171–174. [Google Scholar] [CrossRef]
- Wang, Y.S.; Tian, S.P.; Xu, Y.; Qin, G.Z.; Yao, H. Changes in the activities of pro- and anti-oxidant enzymes in peach fruit inoculated with Cryptococcus laurentii or Penicillium expansum at 0 or 20 °C. Postharvest Biol. Technol. 2004, 34, 21–28. [Google Scholar] [CrossRef]
- Beers, J.R.F.; Sizer, I.W. A spectrophotometric method for measuring the breakdown of hydrogen peroxide by catalase. J. Biol. Chem. 1952, 95, 133–140. [Google Scholar] [CrossRef]
- Kurabachew, H.; Wydra, K. Characterization of plant growth promoting rhizobacteria and their potential as bioprotectant against tomato bacterial wilt caused by Ralstonia solanacearum. Biol. Control 2013, 67, 75–83. [Google Scholar] [CrossRef]
- Matića, S.; Spadaroa, D.; Garibaldia, A.; Gullinoa, M.L. Antagonistic yeasts and thermotherapy as seed treatments to control Fusarium fujikuroi on rice. Biol. Control 2014, 73, 59–67. [Google Scholar] [CrossRef]
- Kurtzman, C.P.; Fell, J.W. The Yeasts: Taxonomic Study; Elsevier Science: Amsterdam, The Netherlands, 1998. [Google Scholar]
- Druvefors, U. Yeast Biocontrol of Grain Spoilage Mold. Ph.D. Thesis, Swedish University of Agricultural Sciences, Uppsala, Sweden, 2004. [Google Scholar]
- Janisiewicz, W.J.; Tworkoski, T.J.; Kurtzman, C.P. Biocontrol potential of Metchnikowia pulcherrima strains against blue mold of apple. Phytopathology 2001, 91, 1098–1108. [Google Scholar] [CrossRef] [PubMed]
- Kurtzman, C.P.; Droby, S. Metschnikowia fructicola, a new ascosporic yeast with potential for biocontrol of postharvest fruit rots. Syst. Appl. Microbiol. 2001, 24, 395–399. [Google Scholar] [CrossRef]
- Zheng, X.D.; Zhang, H.Y.; Sun, P. Biological control of postharvest green mold decay of oranges by Rhodotorula glutinis. Eur. Food Res. Technol. 2005, 220, 353–357. [Google Scholar] [CrossRef]
- Pertot, I.; Giovannini, O.; Benanchi, M.; Caffi, T.; Rossi, V.; Mugnai, L. Combining biocontrol agents with different mechanisms of action in a strategy to control Botrytis cinerea on grapevine. Crop. Prot. 2017, 97, 85–93. [Google Scholar] [CrossRef]
- Alvindia, D.G.; Natsuaki, K.T. Evaluation of fungal epiphytes isolated from banana fruit surfaces for biocontrol of banana crown rot disease. Crop. Prot. 2008, 27, 1200–1207. [Google Scholar] [CrossRef]
- Li, L.; Ma, J.; Li, Y.; Wang, Z.; Gao, T.; Wang, Q. Screening and partial characterization of Bacillus with potential applications in biocontrol of cucumber Fusarium wilt. Crop. Prot. 2012, 35, 29–35. [Google Scholar] [CrossRef]
- Narayanasamy, P. Biological Management of Diseases of Crops; Springer: New York, NY, USA, 2013. [Google Scholar]
- Zhang, D.; Spadaro, D.; Garibaldi, A.; Gullino, M.L. Selection and evaluation of new antagonists for their efficacy against postharvest brown rot of peaches. Postharvest Biol. Technol. 2010, 55, 174–181. [Google Scholar] [CrossRef]
- Sharma, N. Biological Controls for Preventing Food Deterioration; Wiley Blackwell: Chichester, UK, 2014. [Google Scholar]
- Sharma, R.R.; Singh, D.; Singh, R. Biological control of postharvest diseases of fruits and vegetables by microbial antagonists: A review. Biol. Control 2009, 50, 205–221. [Google Scholar] [CrossRef]
- Droby, S.; Chalutz, E.; Wilson, C.L. Antagonistic microorganisms as biocontrol agents of postharvest diseases of fruit and vegetables. Postharvest News Inf. 1991, 2, 169–173. [Google Scholar]
- Janisiewicz, W.J. Biocontrol of postharvest diseases of temperate fruits: Challenges and opportunities. In Plant-Microbe Interactions and Biological Control; Boland, J., Kuykendall, L.D., Eds.; Marcel Dekker: New York, NY, USA, 1998. [Google Scholar]
- El Ghaouth, A.; Wilson, C.L.; Wisniewski, M.E. Biologically-based alternatives to synthetic fungicides for the postharvest diseases of fruit and vegetables. In Diseases of Fruit and Vegetables; Naqvi, S.A.M.H., Ed.; Springer: Dordrecht, The Netherlands, 2004. [Google Scholar]
- Zhang, D.; Spadaro, D.; Garibaldi, A.; Gullino, M.L. Potential biocontrol activity of a strain of Pichia guilliermondii against grey mold of apples and its possible modes of action. Biol. Control 2011, 57, 193–201. [Google Scholar] [CrossRef]
- Selitrennikoff, C.P. Antifungal proteins. Appl. Environ. Microbiol. 2001, 67, 2883–2894. [Google Scholar] [CrossRef] [PubMed]
- Schmitt, M.J.; Breinig, F. Yeast viral killer toxins: Lethality and self-protection. Nat. Rev. Microbiol. 2006, 4, 212–221. [Google Scholar] [CrossRef]
- Coelho, A.R.; Celli, M.G.; Ono, E.Y.S.; Wosiacki, G. Penicillium expansum versus antagonist yeasts with perspectives of application in biocontrol and patulin degradation. Braz. Arch. Biol. Technol. 2007, 50, 725–733. [Google Scholar] [CrossRef]
- Hashem, M.; Alamri, S. The biocontrol of postharvest disease (Botryodiplodia theobromae) of guava (Psidium guajava L.) by the application of yeast strains. Postharvest Biol. Technol. 2009, 53, 123–130. [Google Scholar] [CrossRef]
- Muccilli, S.; Wemhoff, S.; Restuccia, C.; Meinhardt, F. Exoglucanase-encoding genes from three Wickerhamomyces anomalus killer strains isolated from olive brine. Yeast 2013, 30, 33–43. [Google Scholar] [CrossRef]
- Marquina, D.; Santos, A.; Peinado, J.M. Biology of killer yeasts. Int. Microbiol. 2002, 5, 65–71. [Google Scholar] [CrossRef] [PubMed]
- Santos, A.; san Mauro, M.; Bravo, E.; Marquina, D. PMKT2, a new killer toxin from Pichia membranifaciens, and its promising biotechnological properties for control of the spoilage yeast Brettanomyces bruxellensis. Microbiology 2009, 155, 624–634. [Google Scholar] [CrossRef]
- Breinig, F.; Tipper, D.J.; Schmitt, M.J. Kre1p, the plasma membrane receptor for the yeast K1 viral toxin. Cell 2002, 108, 395–405. [Google Scholar] [CrossRef]
- Oregel-Zamudio, E.; Angoa-Pérez, M.V.; Oyoque-Salcedo, G.; Aguilar-González, C.N.; Mena-Violante, H.G. Effect of candelilla wax edible coatings combined with biocontrol bacteria on strawberry quality during the shelf-life. Sci. Hortic. 2017, 214, 273–279. [Google Scholar] [CrossRef]
- Wisniewski, M.; Wilson, C.; Hershberger, W. Characterization of inhibition of Rhizopus stolonifer germination and growth by Enterobacter cloacae. Can. J. Bot. 1989, 67, 2317–2323. [Google Scholar] [CrossRef]
- Arras, G.; de-Cicco, V.; Arru, S.; Lima, G. Biocontrol by yeasts of blue mold of citrus fruits and the mode of action of an isolate of Pichia guilliermondii. J. Hortic. Sci. 1998, 73, 413–418. [Google Scholar] [CrossRef]
- Droby, S.; Chalutz, E.; Wilson, C.L.; Wisniewski, M.E. Characterization of the biocontrol activity of Debaryomyces hansenii in the control of Penicillium digitatum on grapefruit. Can. J. Microbiol. 1989, 35, 794–800. [Google Scholar] [CrossRef]
- Droby, S.; Cohen, L.; Daus, A.; Weiss, B.; Horev, B.; Chalutz, E.; Katz, H.; Keren-Tzur, M.; Shachnai, A. Commercial testing of aspire: A yeast preparation for the biological control of postharvest decay of citrus. Biol. Control 1998, 12, 97–101. [Google Scholar] [CrossRef]
- Wisniewski, M.; Biles, C.; Droby, S.; McLaughlin, R.; Wilson, C.; Chalutz, E. Mode of action of the postharvest biocontrol yeast, Pichia guilliermondii. I. Characterization of attachment to Botrytis cinerea. Physiol. Mol. Plant Pathol. 1991, 39, 245–258. [Google Scholar] [CrossRef]
- El Ghaouth, A.; Wilson, C.; Wisniewski, M.; Droby, S.; Smilanick, J.L.; Korsten, L. Biological control of postharvest diseases of fruits and vegetables. Appl. Mycol. Biotechnol. 2002, 2, 219–238. [Google Scholar] [CrossRef]
- Walsh, T.J.; Melcher, G.P.; Lee, J.W.; Pizzo, P.A. Infections due to Trichosporon species: New concepts in mycology, pathogenesis, diagnosis and treatment. Curr. Top. Med. Mycol. 1993, 5, 79–113. [Google Scholar]
- Arnaldo, L.C.; Padovan, A.C.B.; Chaves, G.M. Current Knowledge of Trichosporon spp. and Trichosporonosis. Clin. Microbiol. Rev. 2011, 24, 682–700. [Google Scholar] [CrossRef]

| Yeast Isolate | Percentage Inhibition of Radial Growth (PIRG) (%) |
|---|---|
| F001 | 59.46 ± 5.41 abc z |
| F002 | 50.00 ± 4.05 bcde |
| F006 | 60.81 ± 1.35 ab |
| F010 | 28.38 ± 1.35 hi |
| F015 | 45.95 ± 2.70 cdef |
| F022 | 32.43 ± 2.70 ghi |
| F026 | 54.05 ± 0.00 bcde |
| L003 | 59.46 ± 8.11 abc |
| FL002 | 31.08 ± 1.35 ghi |
| FL006 | 35.14 ± 2.70 fgh |
| FL013 | 70.27 ± 0.00 a |
| FL015 | 36.49 ± 1.35 fgh |
| FL016 | 54.05 ± 0.00 bcde |
| FP001 | 40.54 ± 2.70 efgh |
| FP002 | 54.05 ± 0.00 bcde |
| FP006 | 54.05 ± 2.70 bcde |
| FP013 | 36.49 ± 1.35 fgh |
| FP014 | 51.35 ± 2.70 bcde |
| LP005 | 41.89 ± 1.35 defg |
| LP010 | 59.46 ± 8.11 abc |
| FLP004 | 33.78 ± 4.05 fghi |
| FLP007 | 54.05 ± 0.00 bcde |
| FLP009 | 52.03 ± 2.03 bcde |
| FLP011 | 21.62 ± 2.70 i |
| FLP016 | 50.00 ± 1.35 bcde |
| Treatment | Diameter of Mycelial Growth (cm) |
|---|---|
| Control | 6.82 ± 0.20 a z |
| F001 | 1.96 ± 0.88 c |
| F006 | 0.80 ± 0.35 cd |
| L003 | 2.25 ± 0.33 c |
| FL013 | 0.00 ± 0.00 d |
| LP010 | 4.73 ± 0.37 b |
| Treatment | Lesion Diameter (cm) | Lesion Expansion (cm day−1) | Disease Reduction over Control (%) |
|---|---|---|---|
| Control | 4.08 ± 0.06 a z | 0.68 ± 0.01 a | -- |
| F001 | 1.99 ± 0.17 d | 0.33 ± 0.03 d | 51.19 ± 4.17 a |
| F006 | 3.45 ± 0.22 bc | 0.58 ± 0.04 bc | 15.44 ± 5.48 bc |
| L003 | 3.68 ± 0.08 ab | 0.61 ± 0.01 ab | 9.93 ± 1.94 c |
| FL013 | 3.13 ± 0.19 c | 0.52 ± 0.03 c | 23.20 ± 4.77 b |
| LP010 | 3.62 ± 0.14 ab | 0.60 ± 0.02 ab | 11.36 ± 3.37 bc |
| Solution | Spore Germination (%) |
|---|---|
| Sterile distilled water | 100.0 ± 0.00 a z |
| Benocide 50WP® | 78.6 ± 3.62 c |
| F001 5 × 104 cells mL−1 | 89.5 ± 0.25 b |
| F001 5 × 106 cells mL−1 | 48.9 ± 1.41 e |
| F001 5 × 108 cells mL−1 | 30.3 ± 1.77 f |
| FL013 5 × 104 cells mL−1 | 76.2 ± 1.16 c |
| FL013 5 × 106 cells mL−1 | 67.0 ± 4.15 d |
| FL013 5 × 108 cells mL−1 | 64.3 ± 2.99 d |
| Treatment | Mycelia Growth Diameter (cm) |
|---|---|
| Sterile distilled water (SDW) | 6.91 ± 0.09 a z |
| F001 5 × 108 cells mL−1 | 0.00 ± 0.00 c |
| FL013 5 × 108 cells mL−1 | 5.69 ± 0.50 b |
| Treatment | Disease Incidence (%) | Disease Severity (%) |
|---|---|---|
| Sterile distilled water | 100 ± 0.00 a z | 75 ± 13.7 a |
| Trichosporon asahii | 66.7 ± 14.43 a | 25 ± 9.1 b |
| Treatment | PPO (Unit g−1 Tissue) | PAL (Unit g−1 Tissue) | CAT (U g−1 FW) |
|---|---|---|---|
| Sterile distilled water | 274.6 ± 4.8 a z | 2012.7 ± 11.4 a | 2.34 ± 0.3 a |
| Trichosporon asahii | 274.3 ± 5.9 a | 1986.0 ± 13.6 a | 2.27 ± 0.4 a |
Publisher’s Note: MDPI stays neutral with regard to jurisdictional claims in published maps and institutional affiliations. |
© 2021 by the authors. Licensee MDPI, Basel, Switzerland. This article is an open access article distributed under the terms and conditions of the Creative Commons Attribution (CC BY) license (http://creativecommons.org/licenses/by/4.0/).
Share and Cite
Hassan, H.; Mohamed, M.T.M.; Yusoff, S.F.; Hata, E.M.; Tajidin, N.E. Selecting Antagonistic Yeast for Postharvest Biocontrol of Colletotrichum gloeosporioides in Papaya Fruit and Possible Mechanisms Involved. Agronomy 2021, 11, 760. https://doi.org/10.3390/agronomy11040760
Hassan H, Mohamed MTM, Yusoff SF, Hata EM, Tajidin NE. Selecting Antagonistic Yeast for Postharvest Biocontrol of Colletotrichum gloeosporioides in Papaya Fruit and Possible Mechanisms Involved. Agronomy. 2021; 11(4):760. https://doi.org/10.3390/agronomy11040760
Chicago/Turabian StyleHassan, Hamizah, Mahmud Tengku Muda Mohamed, Siti Fairuz Yusoff, Erneeza Mohd Hata, and Nor Elliza Tajidin. 2021. "Selecting Antagonistic Yeast for Postharvest Biocontrol of Colletotrichum gloeosporioides in Papaya Fruit and Possible Mechanisms Involved" Agronomy 11, no. 4: 760. https://doi.org/10.3390/agronomy11040760
APA StyleHassan, H., Mohamed, M. T. M., Yusoff, S. F., Hata, E. M., & Tajidin, N. E. (2021). Selecting Antagonistic Yeast for Postharvest Biocontrol of Colletotrichum gloeosporioides in Papaya Fruit and Possible Mechanisms Involved. Agronomy, 11(4), 760. https://doi.org/10.3390/agronomy11040760

